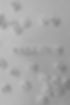
Mission.jpeg

Acerca de

About
Finding Inspiration in Every Turn
We proudly support both direct clients and those referred through the California Department of Rehabilitation, offering personalized career counseling for individuals of all skill levels and experiences. Our team is especially passionate about empowering people with disabilities to pursue meaningful employment and long-term career success.
Beyond client services, we actively partner with Bay Area employers to open doors for diverse talent and to help organizations strengthen their own diversity and inclusion programs in finding creative ways to provide reasonable employee accommodations.
Whether building resumes, preparing for interviews, navigating job searches, or providing on-the-job coaching, our career counselors are dedicated to translating each client’s unique strengths into opportunities where they can thrive.
Mission
At Trends Careers, our mission is to empower individuals of all abilities—including those who are differently abled—to achieve meaningful employment. We partner with each client to design creative, personalized career pathways that foster independence, confidence, and long-term success.

Vision
To redefine career planning by creating clear, scalable pathways that help every client reach their ultimate professional goals.
Our Values
We are guided by principles that shape how we serve our clients, employers, and community:
-
Equity – Clients are the center of our work.
-
Compassion – Guiding with patience, understanding, and respect.
-
Advocacy – Educating employers on our clients' values.
-
Integrity – Building trust through honesty and transparency.
-
Growth – Embracing change to better serve our clients.
-
Relationships – Strengthening connections with clients
-
Solution-Focused – Identifying transferable skills and adapting them creatively to open employment opportunities.


Our Goals
We empower clients with lifelong career tools that foster independence and growth, reduce unemployment within the differently abled community through coaching and opportunity, and promote fair, inclusive employment practices for all.
Our Clients



